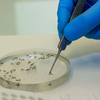
image

Pará e outros 12 estados relatam casos da febre oropouche
Os sintomas incluem dor de cabeça, muscular, nas articulações, náusea e diarreia

O Ministério da Saúde fez um alerta para o aumento e a disseminação da febre do oropouche no Brasil. Segundo o órgão, até o dia 13 de março, o País contabilizava 5.102 casos da doença, número cinco vezes maior do que o registrado no ano passado (832). Os sintomas são parecidos com os da dengue e da chikungunya: dor de cabeça, muscular, nas articulações, náusea e diarreia.
VEJA MAIS
Entre os casos registrados até o momento, 2.947 estão no Amazonas e 1.528 em Rondônia. No entanto, já há ocorrências em outros 11 Estados: Bahia, Acre, Espírito Santo, Pará, Rio, Piauí, Roraima, Santa Catarina, Amapá, Maranhão e Paraná.
Para o governo, o principal motivo por trás do aumento no número de casos é a descentralização da distribuição dos testes para diagnóstico. As informações são do jornal O Estado de S. Paulo.
COMPARTILHE ESSA NOTÍCIA